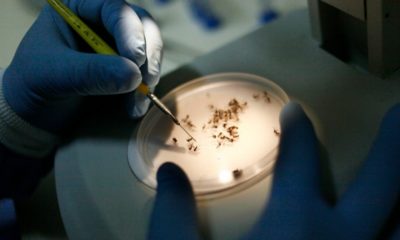
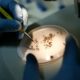

O estado do Rio de Janeiro já iniciou uma mobilização para conter o avanço da bronquiolite, doença respiratória que preocupa autoridades de saúde principalmente nos meses...


O Centro de Informações Estratégicas de Vigilância em Saúde do Estado (CIEVS/SES-RJ) emitiu, nesta quarta-feira (24), um alerta para os 92 municípios do Rio de Janeiro...


A nova edição do Panorama Covid-19 da Secretaria de Estado de Saúde, divulgada nesta terça-feira (08), apresenta aumento no atendimento das Unidades de Pronto Atendimento 24h...


A Secretaria Estadual de Saúde lançou, nesta segunda (19), a campanha “Vape é Jogo Sujo”, de conscientização sobre o uso de cigarros eletrônicos. O objetivo da...

Sorotipo 3 não circulava no estado do Rio desde 2007, o que amplia a margem de pessoas que nunca tiveram contato com o vírus


A Secretaria de Estado de Saúde do Rio de Janeiro decidiu manter o decreto que classifica como epidemia por dengue a evolução de casos da doença...


O número de atendimentos de pacientes com dengue nas unidades de saúde do estado do Rio caiu 16% na última semana em relação à semana anterior....


Ação promovida pela Secretaria de Estado de Saúde, acontece neste sábado (2), no Parque das Figueiras, na Lagoa, Zona Sul do Rio


De acordo com a Secretaria Estadual de Saúde (SES), foram registrados 302 casos da doença até o dia 20 de fevereiro


Campanha é uma parceria do Hemorio, Secretaria Estadual de Saúde e Suderj